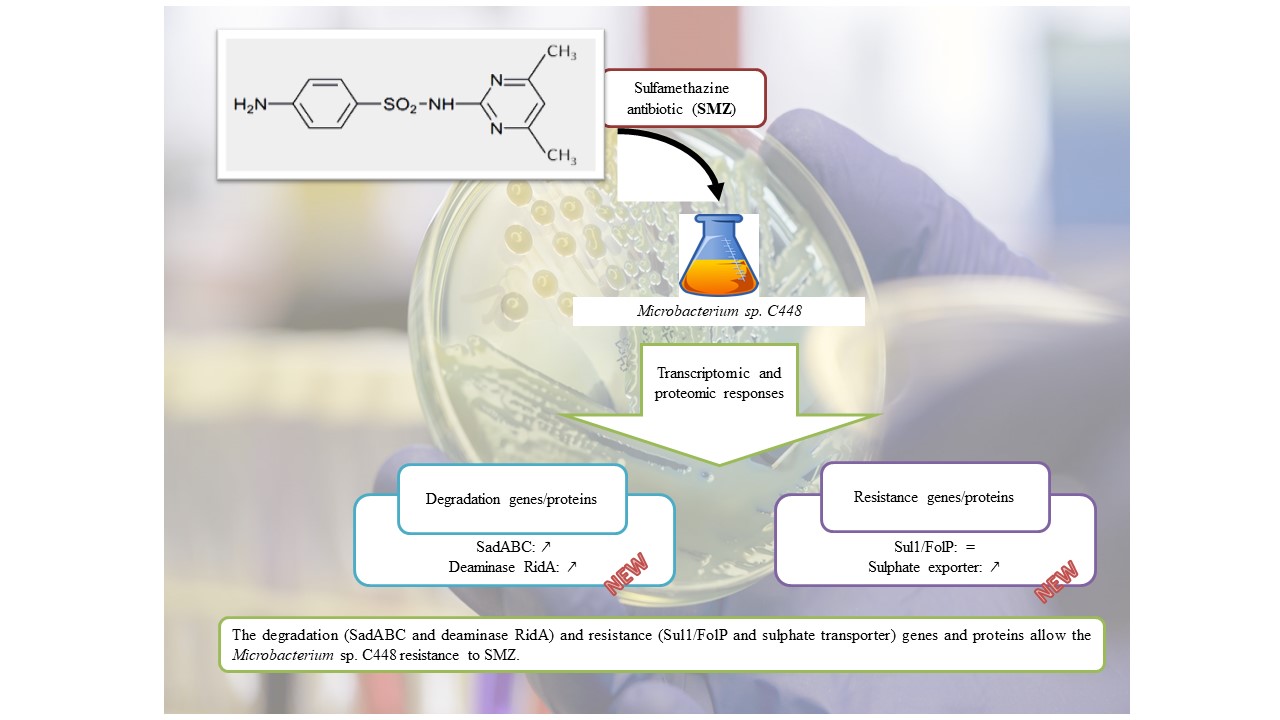

Le 4 juil. 2023
Sciences de la vie santé et environnement
Résistance et dégradation de la sulfaméthazine par Microbacterium
Publié le 10 juillet 2023 – Mis à jour le 10 juillet 2023
Effet des concentrations subthérapeutiques et thérapeutiques de sulfaméthazine sur les gènes transcrits et les protéines traduites impliqués dans la résistance et la dégradation de Microbacterium sp. C448
Microbacterium sp. C448, isolé d'un sol régulièrement exposé à la sulfaméthazine (SMZ), peut utiliser divers antibiotiques sulfonamides comme seule source de carbone pour sa croissance. La base de la régulation des gènes codant pour la voie métabolique des sulfonamides, la dihydroptéroate synthase cible des sulfonamides (folP) et les gènes de résistance aux sulfonamides (sul1) est inconnue chez cet organisme.
Dans la présente étude, la réponse du transcriptome et du protéome de Microbacterium sp. C448 après exposition à des concentrations subthérapeutiques (33 ?M) ou thérapeutiques (832 ?M) de SMZ a été évaluée.
La concentration thérapeutique a induit l'expression et la production de Sad les plus élevées, en accord avec l'activité de dégradation du SMZ observée in cellulo. Après la dégradation complète du SMZ, la production de Sad a eu tendance à revenir au niveau basal observé avant l'exposition au SMZ. La cinétique transcriptomique et protéomique était concomitante pour les gènes et les protéines de résistance. L'abondance de la protéine Sul1, 100 fois plus abondante que la protéine FolP, n'a pas changé en réponse à l'exposition au SMZ.
De plus, des analyses non ciblées ont mis en évidence l'augmentation de l'expression et de la production d'une désaminase RidA et d'un exportateur de sulfate putatif. Ces deux nouveaux facteurs impliqués respectivement dans la dégradation du métabolite 4-aminophénol et dans l'exportation des résidus de sulfate formés lors de la dégradation du SMZ ont permis de mieux comprendre le processus de détoxification du SMZ par Microbacterium sp. C448.
https://lmge.uca.fr/actualites/resistance-et-degradation-de-la-sulfamethazine-par-microbacterium#/admin
Dans la présente étude, la réponse du transcriptome et du protéome de Microbacterium sp. C448 après exposition à des concentrations subthérapeutiques (33 ?M) ou thérapeutiques (832 ?M) de SMZ a été évaluée.
La concentration thérapeutique a induit l'expression et la production de Sad les plus élevées, en accord avec l'activité de dégradation du SMZ observée in cellulo. Après la dégradation complète du SMZ, la production de Sad a eu tendance à revenir au niveau basal observé avant l'exposition au SMZ. La cinétique transcriptomique et protéomique était concomitante pour les gènes et les protéines de résistance. L'abondance de la protéine Sul1, 100 fois plus abondante que la protéine FolP, n'a pas changé en réponse à l'exposition au SMZ.
De plus, des analyses non ciblées ont mis en évidence l'augmentation de l'expression et de la production d'une désaminase RidA et d'un exportateur de sulfate putatif. Ces deux nouveaux facteurs impliqués respectivement dans la dégradation du métabolite 4-aminophénol et dans l'exportation des résidus de sulfate formés lors de la dégradation du SMZ ont permis de mieux comprendre le processus de détoxification du SMZ par Microbacterium sp. C448.
Retrouvez la publication originale:
Paris L, Devers-Lamrani M, Joly M, Viala D, De Antonio M, Pereira B, Rouard N, Besse-Hoggan P, Hébraud M, Topp E, Martin-Laurent F, Batisson I. Effect of subtherapeutic and therapeutic sulfamethazine concentrations on transcribed genes and translated proteins involved in Microbacterium sp. C448 resistance and degradation. FEMS Microbiol Ecol. 2023 Jun 16;99(7):fiad064. doi: 10.1093/femsec/fiad064. PMID: 37309049https://lmge.uca.fr/actualites/resistance-et-degradation-de-la-sulfamethazine-par-microbacterium#/admin
